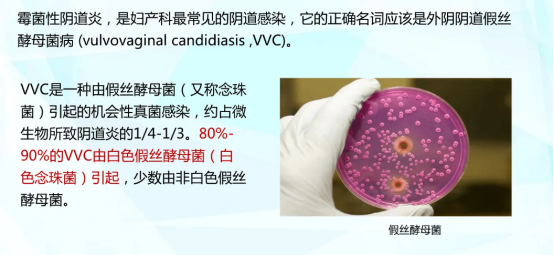

相信現(xiàn)在大部分人都存在著腸胃問題,便秘問題反反復(fù)復(fù),為了解決這些問題,市面上就出現(xiàn)了很多益生菌,產(chǎn)品種類很豐富,不過大多數(shù)人可能對品牌不太了解,下面就整體了10種口碑比較好的益生菌品牌,大家感興趣的可以看看。

益生菌十大品牌排行
1、BIOSTIME合生元
2、life space益倍適
3、湯臣倍健
4、媽咪愛
5、Culturelle康萃樂
6、Swanson斯旺森
7、漢臣氏
8、Nemans紐曼思
9、普瑞寶
10、wonderlab
1、BIOSTIME合生元益生菌

合生元是國內(nèi)品牌,和法國公司合作,擁有先進(jìn)的生產(chǎn)設(shè)備和工藝,專注母嬰健康,益生菌產(chǎn)品主要以兒童為主,嬰幼兒和兒童都有適用的產(chǎn)品,成人款比較少,價格來說也不貴,在200-300左右。
2、life space益倍適益生菌

life space益倍適是澳大利亞品牌,是澳洲益生菌知名品牌,專業(yè)生產(chǎn)高端益生菌,產(chǎn)品涵蓋人體全生命周期,適應(yīng)每一個階段的健康需求,成人、兒童都有適用的產(chǎn)品,而且價格也實惠,在100-300元左右。
3、湯臣倍健益生菌

湯臣倍健是中國膳食營養(yǎng)補充劑領(lǐng)導(dǎo)品牌和標(biāo)桿企業(yè),產(chǎn)品涵蓋范圍廣,擁有專業(yè)的“透明工廠”,多年來始終堅持優(yōu)選原料、注重品控,以價格實惠(200元左右)和高品質(zhì)受到廣大消費者的喜愛。
4、媽咪愛益生菌

媽咪愛益生菌是韓美集團(tuán)旗下產(chǎn)品,是知名度的益生菌品牌,益生菌產(chǎn)品主要以兒童為主,多次獲得“中國醫(yī)藥市場兒童用藥值得信賴品牌”獎,價格來說算是便宜的了,都在百元以內(nèi),最低價格不到20元。
5、Culturelle康萃樂益生菌

Culturelle康萃樂是美國保健品企業(yè)i-Health公司旗下的益生菌膳食補充劑品牌,是美國益生菌行業(yè)領(lǐng)先品牌,該產(chǎn)品已經(jīng)被證明有助于維持兒童天然免疫系統(tǒng)和緩解偶發(fā)性消化不良。在國內(nèi)的知名度也不錯,而且價格也不貴,100-200出頭。
6、Swanson斯旺森益生菌

Swanson斯旺森是來自美國的保健品牌,連續(xù)5年蟬聯(lián)美國消費者最滿意的產(chǎn)品榜單,也被美國國家衛(wèi)生基金會GMP標(biāo)準(zhǔn)檢驗設(shè)定為A級保健品,在質(zhì)量方面值得信賴。它在國內(nèi)算是比較小眾的品牌,知名度不高,價格也在200左右。
7、漢臣氏益生菌

漢臣氏是一個國產(chǎn)品牌,是長期致力于打造健康產(chǎn)業(yè)的品牌,擁有自主研發(fā)實驗室,采用天然高品質(zhì)原料及國際最新生產(chǎn)工藝(如優(yōu)良菌種馴化技術(shù)、超低溫冷凍干燥技術(shù)、第四代生物螯合技術(shù)),安全起效,吸收好,價格稍微貴一點在400左右。
8、Nemans紐曼思益生菌

Nemans紐曼思是中國母嬰營養(yǎng)品品牌,選用來自丹麥科漢森的優(yōu)秀菌株,產(chǎn)品品質(zhì)嚴(yán)控,主要解決孕婦,普通成人,嬰幼兒,兒童等腸胃道健康和免疫系統(tǒng)癥狀。它的知名度沒有合生元高,價格也要貴一點,在300-400左右。
9、普瑞寶益生菌

普瑞寶是杭州民生藥業(yè)有限公司生產(chǎn)的益生菌類產(chǎn)品,擁有微膠囊國際專利技術(shù)和國際專利號,也獲得了國家批準(zhǔn)的保健食品批文,價格比較便宜,屬于百元產(chǎn)品。
10、wonderlab益生菌

wonderlab品牌創(chuàng)立于2017年,主營產(chǎn)品種類多,與全球領(lǐng)先的益生菌供應(yīng)商企業(yè)科漢森UREX合作,推出了針對女性私護(hù)場景的益生菌產(chǎn)品,也是國內(nèi)首款瓶裝女性益生菌。它的淘寶銷量跟合生元、life space益倍適差不多(月銷近萬),價格在100-300左右。